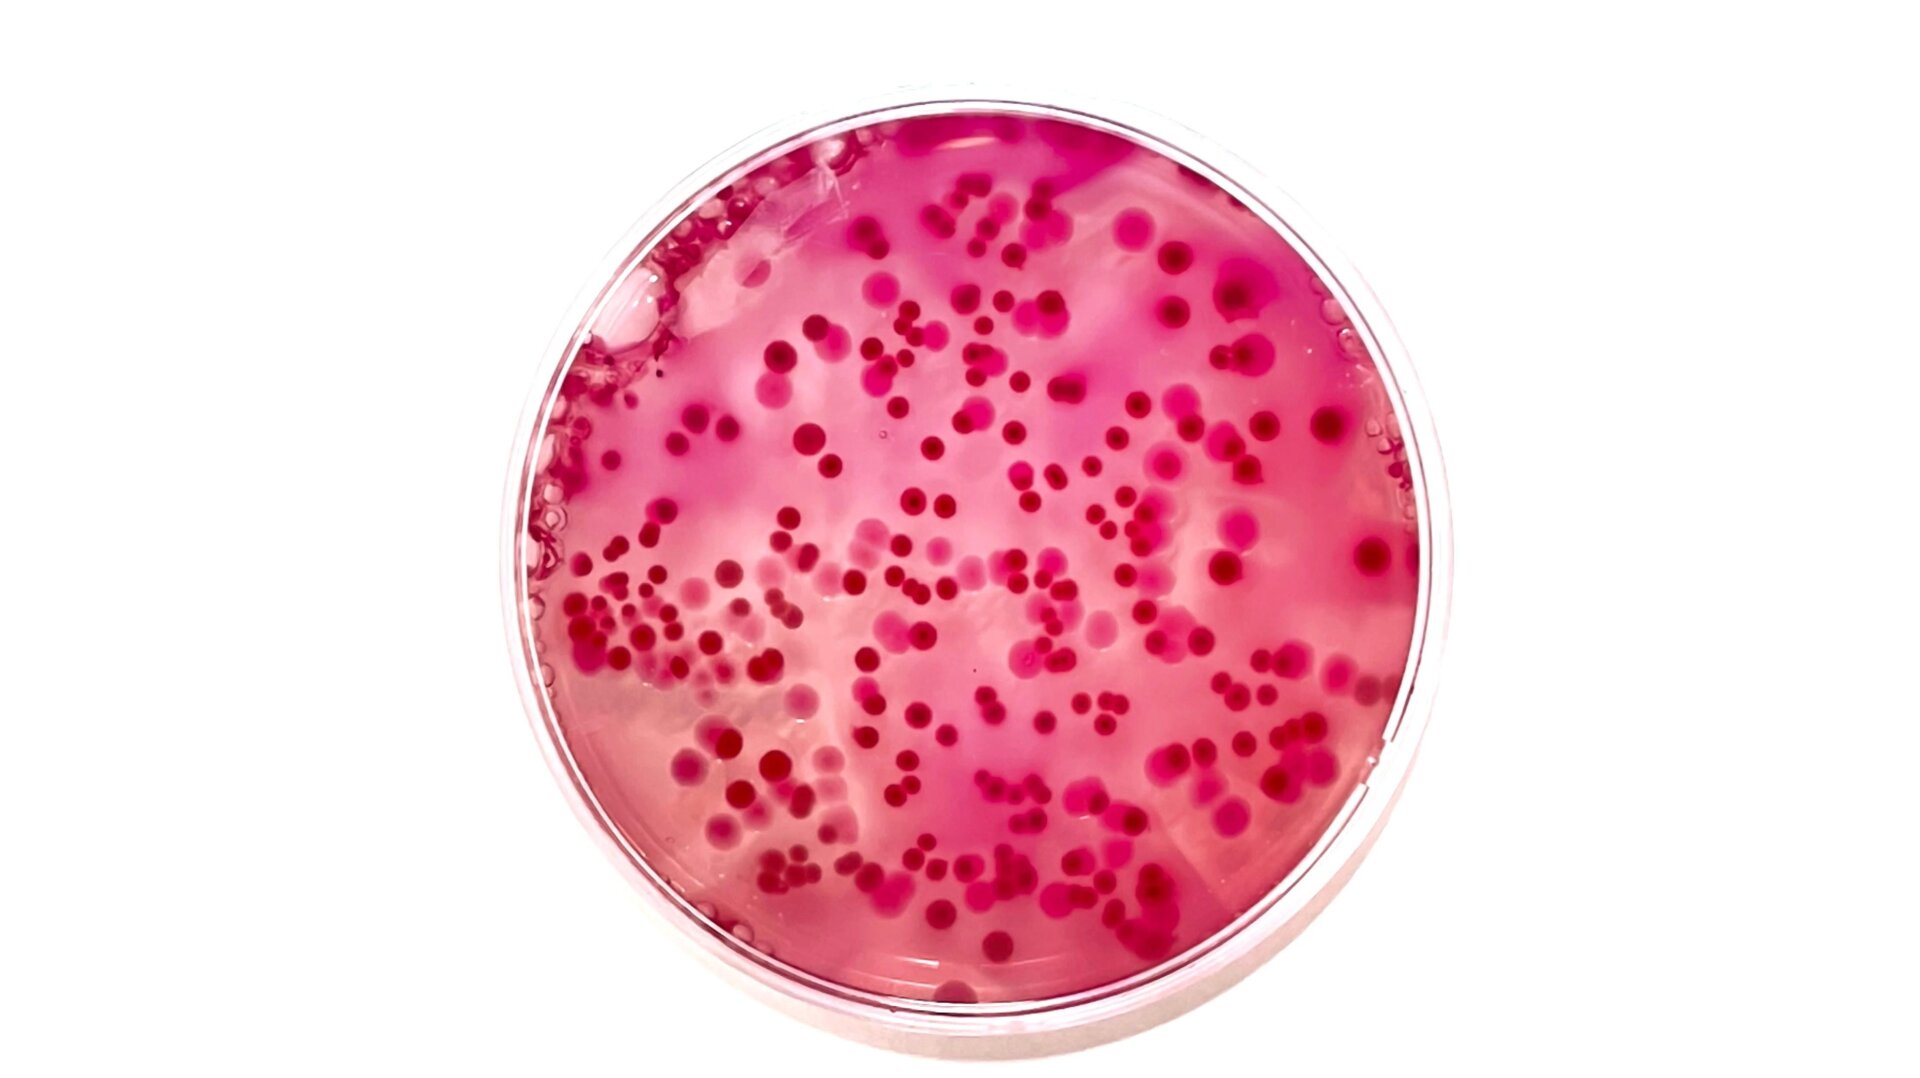

En un estudio realizado este mes, investigadores suizos dicen que secuenciaron genéticamente docenas de especies bacterianas previamente desconocidas que se encontraron en muestras de pacientes. Si bien muchas de estas nuevas bacterias podrían no dañar a los humanos, el equipo identificó varias que probablemente puedan causar enfermedades.
La investigación fue realizada por científicos de la Universidad de Basilea y el Hospital Universitario de Basilea en Suiza. Desde 2014, el equipo ha estado recolectar muestras de sangre o tejido de ciertos pacientes suyos para un proyecto especial. Los médicos analizarán rutinariamente las muestras de los pacientes para encontrar bacterias que puedan ser una causa plausible de la enfermedad de alguien. Los autores del estudio idearon un algoritmo para identificar muestras donde los métodos de prueba convencionales no habían logrado cualquier bacteria conocida. Luego secuenciaron todo el material genético encontrado dentro de estas muestras, con la esperanza de encontrar especies de bacterias no descubiertas previamente.
En total, encontraron 61 especies de bacterias acechando dentro de estas misteriosas muestras. De ellas, 35 parecen nunca haber sido documentadas hasta ahora. . Algunas de las otras bacterias “difíciles de identificar” fueron descubiertas recientemente y nombradas por otros investigadores. Los hallazgos del equipo son publicado este mes en la revista BMC Microbiology.
“Nuestro nuevo algoritmo demostró ser una poderosa herramienta para la detección e identificación de nuevos organismos bacterianos”, escribieron los autores en su artículo.
La mayoría de las bacterias y otros microorganismos que viven dentro o sobre nuestro cuerpo son inofensivos o beneficiosos para nuestra salud. Pero los investigadores no identifique siete especies de estas nuevas bacterias que se consideran “clínicamente relevantes», lo que significa que son probablemente capaces de causar enfermedades. E incluso Las bacterias generalmente inofensivas pueden a veces ser peligrosas dependiendo de las circunstancias, como las bacterias de la piel que entran en una herida recién abierta o infecciones oportunistas. en personas que se vuelven inmunocomprometidas.
Hoy en día, es difícil que los laboratorios clínicos queden perplejos y no logren identificar una causa potencial de la infección de una persona. Pero lo estamos todavía encontrando regularmente Nuevos gérmenes que existen. La secuenciación del genoma completo se puede utilizar para detectar estos microbios desconocidos, pero puede ser una tarea costosa y relativamente proceso largo. Así que los investigadores esperan que su algoritmo, denominado NOVA, abreviatura de Verificación y Análisis de Organismos Noveles, pueda ayudar a otros científicos a acelerar este proceso. trabajo importante.
El equipo está trabajando actualmente para nombrar sus nuevos descubrimientos, con dos nombres propuestos. ya enviado para la consideración de la comunidad científica. También siguen recogiendo muestras y encontrando nuevas bacterias. Entre febrero de 2022 y julio de 2023, según Según su artículo, identificaron otras 21 especies de bacterias potencialmente nuevas.
“Hemos notado una dinámica importante aquí: gracias a los avances tecnológicos en bacteriología, se está publicando mucho más sobre especies recientemente descubiertas de bacterias”, dijo el autor del estudio y microbiólogo Daniel Goldenberger en un declaración.